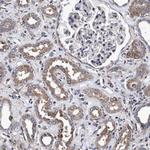
CALCOCO2 Antibody in Immunohistochemistry (Paraffin) (IHC (P))

Search
Invitrogen
CALCOCO2 Polyclonal Antibody
{{$productOrderCtrl.translations['antibody.pdp.commerceCard.promotion.promotions']}}
{{$productOrderCtrl.translations['antibody.pdp.commerceCard.promotion.viewpromo']}}
{{$productOrderCtrl.translations['antibody.pdp.commerceCard.promotion.promocode']}}: {{promo.promoCode}} {{promo.promoTitle}} {{promo.promoDescription}}. {{$productOrderCtrl.translations['antibody.pdp.commerceCard.promotion.learnmore']}}

Please note: We are reviewing Western blot images included in the antibody testing data in our catalog, including those provided by third parties. Unless expressly labeled or annotated as “raw-unedited”, Western blot images included in the antibody testing data in our catalog may have been edited, optimized or otherwise adjusted for presentation.
产品信息
PA5-82807
种属反应
宿主/亚型
分类
类型
抗原
偶联物
形式
浓度
规格
纯化类型
保存液
内含物
保存条件
运输条件
RRID
产品详细信息
Immunogen sequence: SINKKLELKV KEQKDYWETE LLQLKEQNQK MSSENEKMGI RVDQLQAQLS TQEKEMEKLV QGDQDKTEQL EQLKKENDHL FLSLT
Highest antigen sequence indentity to the following orthologs: Mouse - 33%, Rat - 34%.
靶标信息
The protein encoded by this gene is a subunit of nuclear domain 10 (ND10) bodies. ND10 bodies are nuclear domains appearing immunohistochemically as ten dots per nucleus. They are believed to be associated with the nuclear matrix on the basis of their resistance to nuclease digestion and salt extraction. ND10 proteins are removed from the nucleus by herpes simplex virus-1 infection and may have a role in viral life cycles.
仅用于科研。不用于诊断过程。未经明确授权不得转售。
篇参考文献 (0)
生物信息学
蛋白别名: Antigen nuclear dot 52 kDa protein; Calcium-binding and coiled-coil domain-containing protein 2; Nuclear domain 10 protein 52; Nuclear domain 10 protein NDP52; Nuclear dot protein 52
基因别名: CALCOCO2; NDP52
Entrez Gene ID: (Human) 10241




